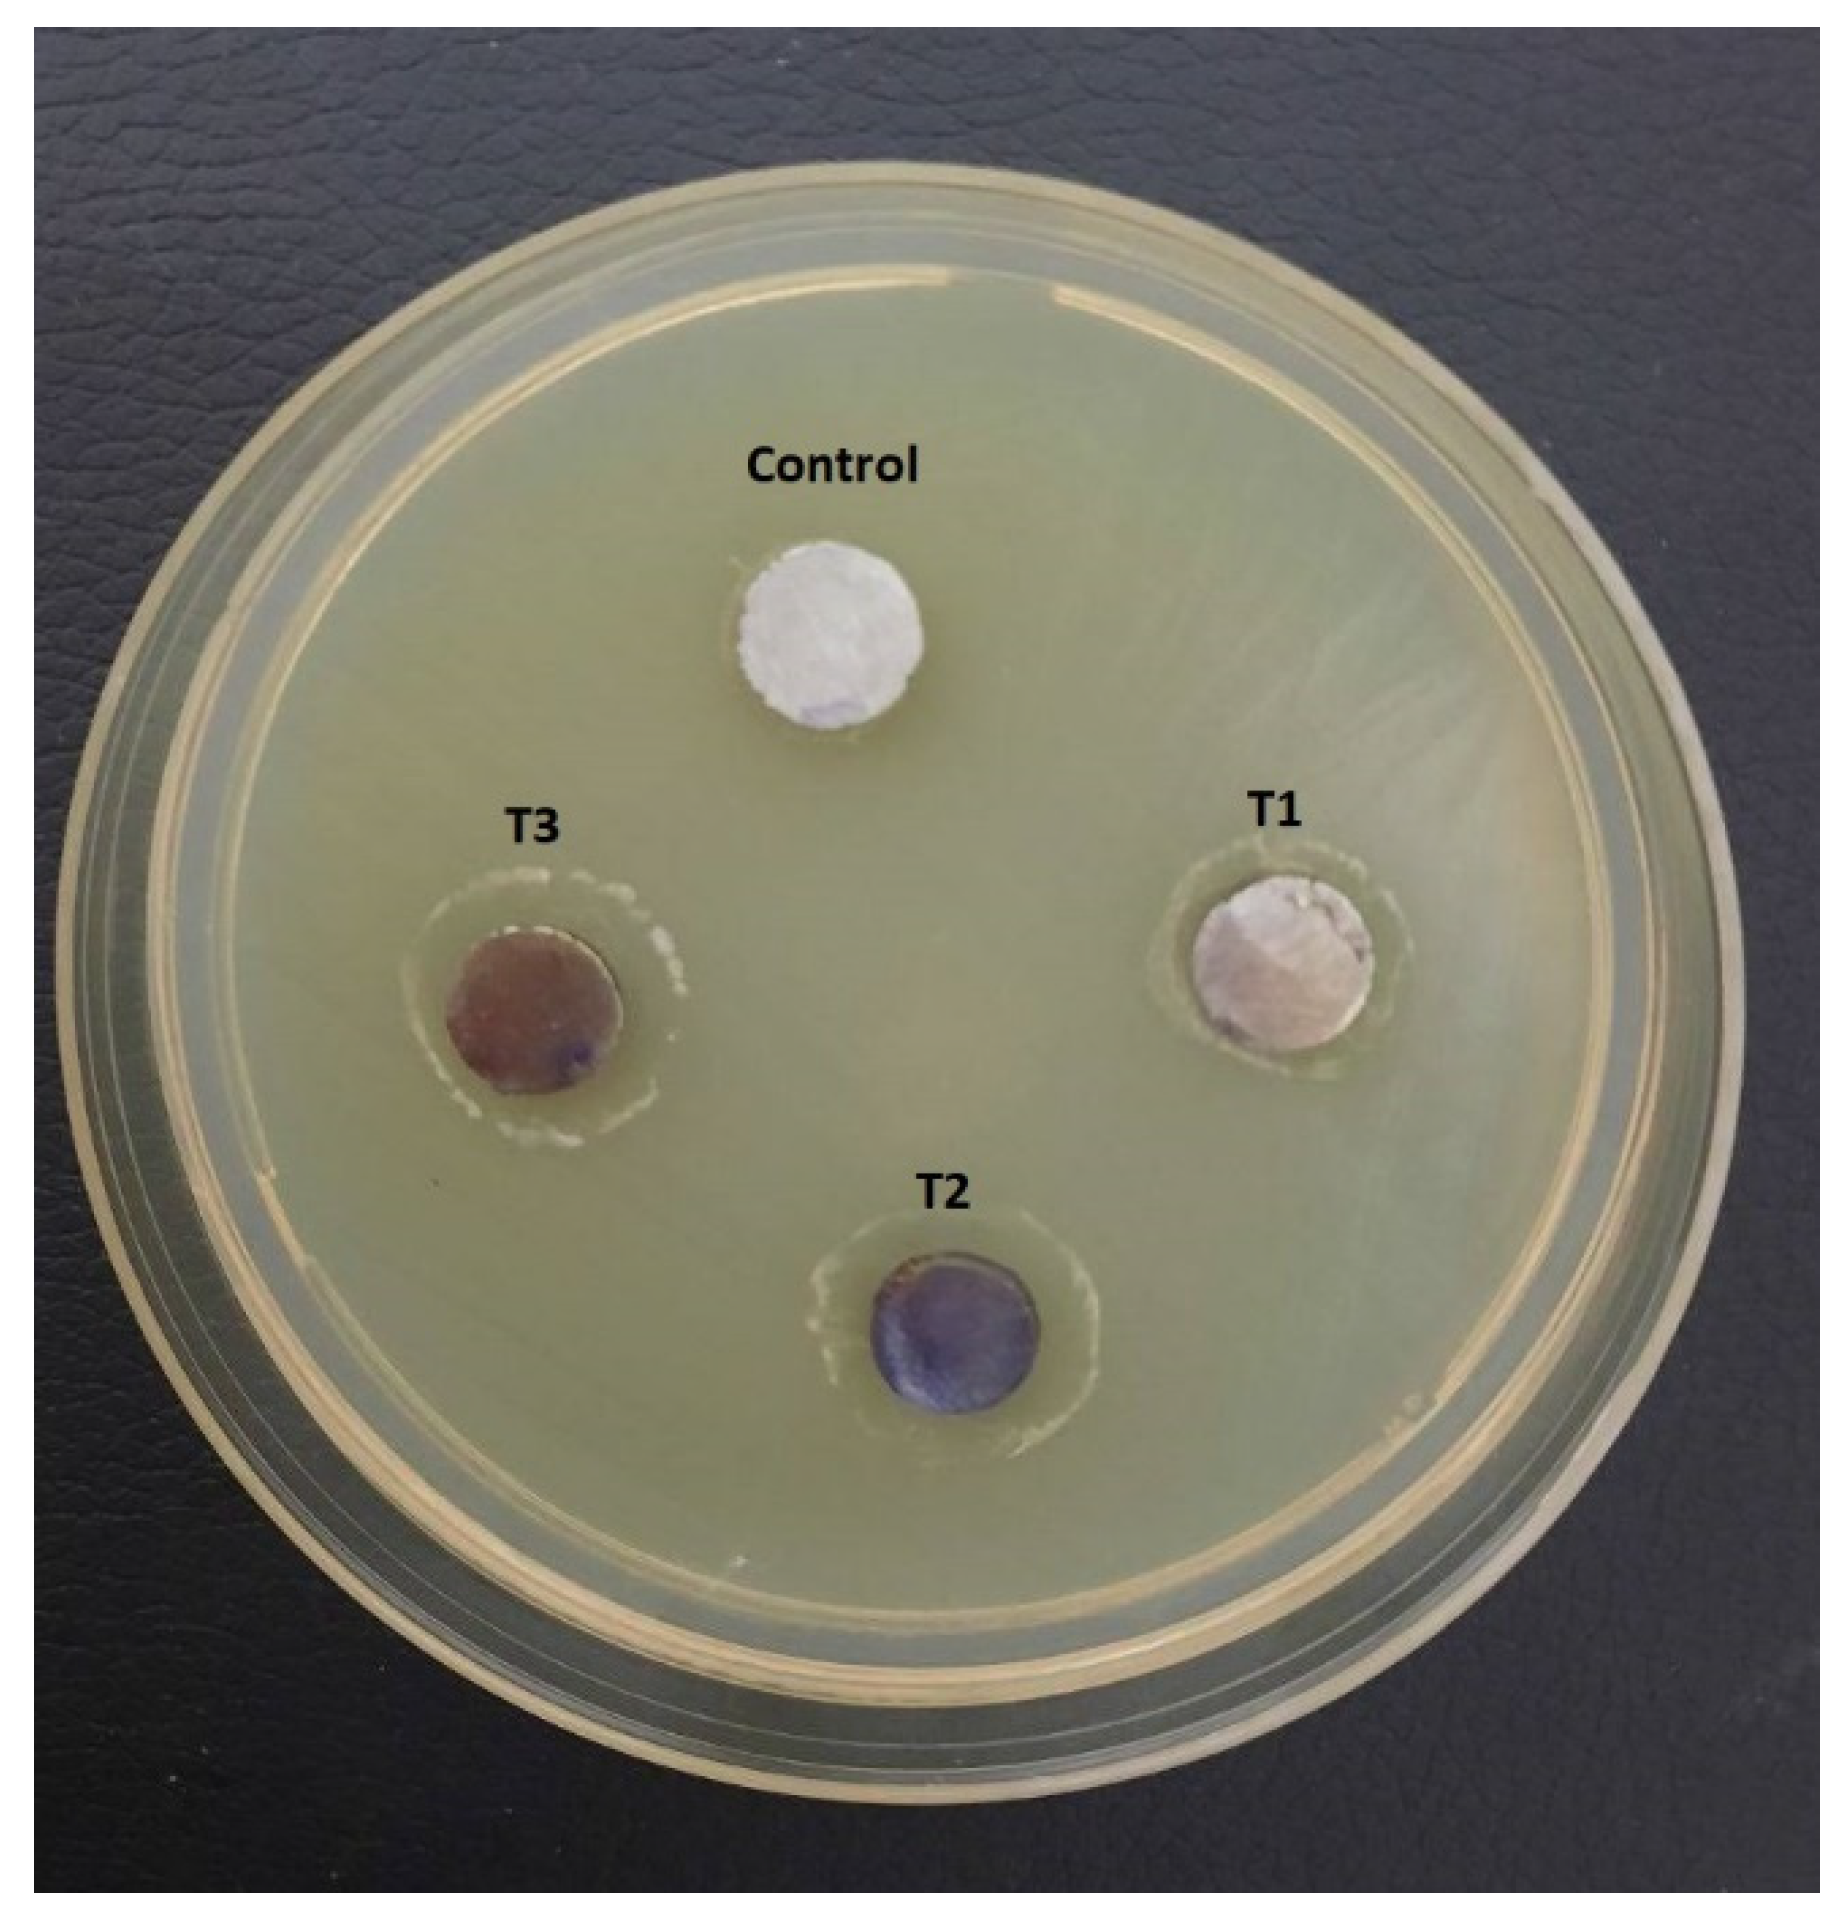

The Effects of Three Antibacterial Nanoparticle Coatings on the Surface Characteristics of Stainless Steel
Abstract
1. Introduction
2. Materials and Methods
2.1. Study Design
2.2. Specimen Preparation
2.3. Nanocoating Procedure
2.4. Characterization of Nanocoated Surfaces
2.5. Antibacterial Procedure
2.6. Statistical Analyses
3. Results
3.1. Surface Morphology and Chemical Composition
3.1.1. Characterization Using FE-SEM
3.1.2. Characterization via EDX Spectroscopy
3.2. X-ray Diffraction
3.3. Microbiological Tests
3.3.1. Antimicrobial Effect of the NP Coating
3.3.2. Zone of Inhibition Test
4. Discussion
5. Conclusions
- (1)
- The DC plasma sputtering system can be used to produce high purity, homogeneous, crack-free nano-coatings of Mo, Ta, and ZnO on 316L SS, with no sign of delamination.
- (2)
- The amount of nanocoating deposited on the substrate is dependent on two factors: coating duration and the type of NP used.
- (3)
- Bacterial strains exposed to surfaces that have been coated with Mo, Ta, and ZnO show a noticeable decrease in their ability to sustain life in a time-dependent manner.
- (4)
- The antibacterial impact of the ZnO NP coating on S. mutans and L. acidophilus is notably greater than that of Ta and Mo NP coatings.
- (5)
- The optimum sputtering coating times to ensure the best antibacterial effect and preserve resources are T1(1) hour for Mo, T3 for Ta (3 h), and T3 (6 h) for ZnO.
Author Contributions
Funding
Data Availability Statement
Conflicts of Interest
References
- Ristic, M.; Vlahovic, S.; Sasic, M.; Zelic, O. Clinical and microbiological effects of fixed orthodontic appliances on periodontal tissues in adolescents. Orthod. Craniofacial Res. 2007, 10, 187–195. [Google Scholar] [CrossRef] [PubMed]
- Toi, C.; Mogodiri, R.; Cleaton-Jones, P.E. Mutans streptococci and lactobacilli on healthy and carious teeth in the same mouth of children with and without dental caries. Microb. Ecol. Health Dis. 2009, 12, 35–41. [Google Scholar] [CrossRef][Green Version]
- Farzin, H.; Mohamad Hadi, M.; Nima, M. Effect of fluoride on nickel-titanium and stainless steel orthodontic archwires: An in-vitro study. J. Dent. 2015, 12, 49–59. [Google Scholar]
- Borzabadi-Farahani, A.; Borzabadi, E.; Lynch, E. Nanoparticles in orthodontics, a review of antimicrobiological and anti-caries application. Acta Odontol. Scand. 2014, 72, 413–417. [Google Scholar] [CrossRef] [PubMed]
- Bapat, R.A.; Joshi, C.P.; Bapat, P.; Chaubal, T.V.; Pandurangappa, R.; Jnanendrappa, N.; Gorain, B.; Khurana, S.; Kesharwani, P. The use of nanoparticles as biomaterials in dentistry. Drug Discov. Today 2019, 24, 85–98. [Google Scholar] [CrossRef] [PubMed]
- Nambi, N.; Shrinivaasan, N.R.; Dhayananth, L.X.; Chajallani, V.G.; George, A.M. Renaissance in orthodontics: Nanotechnology. Int. J. Orthod. Rehabil. 2016, 7, 139. [Google Scholar]
- Bhattacharya, M.; Seong, W.J. Carbon nanotube-based materials—Preparation, biocompatibility, and applications in dentistry. In Nanobiomaterials in Clinical Dentistry, 2nd ed.; Elsevier: Amsterdam, The Netherlands, 2019; pp. 41–76. [Google Scholar]
- Hannig, M.; Kriener, L.; Hoth-Hannig, W.; Becker-Willinger, C.; Schmidt, H. Influence of nanocomposite surface coating on biofilm formation in situ. J. Nanosci. Nanotechnol. 2007, 7, 4642–4648. [Google Scholar] [CrossRef]
- Monteiro, D.R.; Gorup, L.F.; Takamiya, A.S.; Ruvollo-Filho, A.C.; Camargo, E.R.; Barbosa, D.B. The growing importance of materials that prevent microbial adhesion: Antimicrobial effect of medical devices containing silver. Int. J. Antimicrob. Agents 2009, 34, 103–110. [Google Scholar] [CrossRef] [PubMed]
- Cao, W.; Zhang, Y. Novel resin-based dental material with anti-biofilm activity and improved mechanical property by incorporating hydrophilic cationic copolymer functionalized nanodiamond. J. Mater. Sci. Mater. Med. 2018, 29, 162. [Google Scholar] [CrossRef]
- Saafan, A.; Zaazou, M.H.; Sallam, M.K.; Mosallam, O.; El Danaf, H.A. Assessment of Photodynamic Therapy and Nanoparticles Effects on Caries Models. Maced. J. Med. Sci. 2018, 6, 1289–1295. [Google Scholar] [CrossRef]
- Zollfrank, C.; Gutbrod, K.; Wechsler, P.; Guggenbichler, J.P. Antimicrobial activity of transition metal acid MoO3 prevents microbial growth on material surfaces. Mater. Sci. Eng. 2012, C32, 47. [Google Scholar] [CrossRef] [PubMed]
- Qureshi, N.; Patil, R.; Shinde, M. Innovative biofilm inhibition and anti-microbial behavior of molybdenum sulfide nanostructures generated by microwave-assisted solvothermal route. Appl. Nanosci. 2015, 5, 331. [Google Scholar] [CrossRef]
- Shafaei, S.; Lackner, M.; Meier, M.; Plank, J.; Guggenbichler, J.; Zollfrank, C. Polymorphs of molybdenum trioxide as innovative antimicrobial materials. Surf. Innov. 2013, 1, 202. [Google Scholar] [CrossRef]
- Huang, H.; Chang, Y.; Lai, M.; Lin, C.; Lai, C.; Shieh, T. Antibacterial TaN-Ag coatings on titanium dental implants. Surf. Coat. Technol. 2010, 205, 1636–1641. [Google Scholar] [CrossRef]
- Shanaghi, A.; Souri, A.R.; Saedi, H.; Chu, P.K. Effects of the tantalum intermediate layer on the nanomechanical properties and biocompatibility of nanostructured tantalum/tantalum nitride bilayer coating deposited by magnetron sputtering on the nickel titanium alloy. Appl. Nanosci. 2021, 11, 1867–1880. [Google Scholar] [CrossRef]
- Ramazanzadeh, B.; Jahanbin, A.; Yaghoubi, M.; Shahtahmassbi, N.; Ghazvini, K.; Shakeri, M.; Shafaee, H. Comparison of antibacterial effects of ZnO and CuO nanoparticles coated brackets against Streptococcus mutans. J. Dent. 2015, 16, 200. [Google Scholar]
- Rossnagel, S. Sputter Deposition. In Opportunities for Innovation: Advanced Surface Engineering; Sproul, W.D., Legg, K.O., Eds.; Technomic Publishing Co.: Lancaster, PA, USA, 1995. [Google Scholar]
- Geisler, M.; Braatz, C.; Bruch, J.; Kastner, A.; Kress, M.; Ruske, M.; Willms, T.; Zmelty, A. Meeting the demands of modern large area glass coating: Latest developments of horizontal and vertical coaters and applications. Thin Solid Films 2003, 442, 15–20. [Google Scholar] [CrossRef]
- ASTM A240; Standard Specification for Chromium and Chromium-Nickel Stainless Steel Plate, Sheet, and Strip for Pressure Vessels and for General Applications. ASTM International: West Conshohocken, PA, USA, 2022.
- ASTM E-1086; Standard Test Method for Analysis of Austenitic Stainless Steel by Spark Atomic Emission Spectrometry. ASTM International: West Conshohocken, PA, USA, 2022.
- Khan, A.S.; Awais, M. Low-cost deposition of antibacterial ion-substituted hydroxyapatite coatings onto 316L stainless steel for biomedical and dental applications. Coatings 2020, 10, 880. [Google Scholar] [CrossRef]
- Oliveira, D.; Thomson, J.; Alhabeil, J. In vitro Streptococcus mutans adhesion and biofilm formation on different esthetic orthodontic archwires. Angle Orthod. 2021, 91, 786–793. [Google Scholar] [CrossRef]
- Morgan, T.; Wilson, M. The effects of surface roughness and type of denture acrylic on biofilm formation by Streptococcus oralis in a constant depth film fermentor. J. Appl. Microbiol. 2001, 91, 47–53. [Google Scholar] [CrossRef]
- Stanković, A.; Dimitrijević, S.; Uskoković, D. Influence of size scale and morphology on antibacterial properties of ZnO powders hydrothemally synthesized using different surface stabilizing agents. Colloids Surf. B Biointerfaces 2013, 102, 21–28. [Google Scholar] [CrossRef] [PubMed]
- Clinical and Laboratory Standards Institute (CLSI). Performance Standards for Antimicrobial Susceptibility Testing; CLSI Supplement M100-ED-34; Clinical and Laboratory Standards Institute: Wayne, PA, USA, 2024. [Google Scholar]
- Balouiri, M.; Sadiki, M.; Ibnsouda, S.K. Methods for in vitro evaluating antimicrobial activity: A review. J. Pharm. Anal. 2016, 6, 71–79. [Google Scholar] [CrossRef]
- Aqawi, M.; Sionov, R.; Gallily, R.; Friedman, M.; Steinberg, D. Anti-Bacterial properties of Cannabigerol toward Streptococcus mutans. Front. Microbiol. 2021, 12, 656471. [Google Scholar] [CrossRef] [PubMed]
- Ahirwar, S.; Gupta, M.; Snehi, S. Dental caries and lactobacillus: Role and ecology in the oral cavity. Int. J. Pharm. Sci. Res. 2019, 10, 4818–4829. [Google Scholar]
- He, L.; Dai, D.; Xie, L.; Chen, Y.; Zhang, C. Biological effects, applications and strategies of nano modification of dental metal surfaces. Mater. Des. 2021, 207, 109890. [Google Scholar] [CrossRef]
- Zhang, R.; Han, B.; Liu, X. Functional Surface Coatings on Orthodontic Appliances: Reviews of Friction Reduction, Antibacterial Properties, and Corrosion Resistance. Int. J. Mol. Sci. 2023, 24, 6919. [Google Scholar] [CrossRef] [PubMed]
- Mattox, D. Ion plating and ion beam-assisted deposition. In Handbook of Physical Vapor Deposition (PVD) Processing; William Andrew Publishing Norwich: Norwich, NY, USA, 2010; pp. 301–331. [Google Scholar]
- Zeng, S.; Yang, Z.; Hou, Z. Dynamic multifunctional devices enabled by ultrathin metal nanocoatings with optical/photothermal and morphological versatility. Proc. Natl. Acad. Sci. USA 2022, 119, 4. [Google Scholar] [CrossRef] [PubMed]
- Yahya, K. Effect of electrode separation in magnetron DC plasma sputtering on grain size of gold coated samples. Iraqi J. Phys. 2018, 15, 202–210. [Google Scholar] [CrossRef]
- Karthikeyan, K.; Mariappan, P.; Murugan, V.; Sang Jae, K. Nanostructured molybdenum oxide-based antibacterial paint: Effective growth inhibition of various pathogenic bacteria. Nanotechnology 2014, 25, 15101. [Google Scholar]
- Kachoei, M.; Divband, B.; Rahbar, M.; Esmaeilzadeh, M.; Ghanizadeh, M.; Alam, M. A Novel Developed Bioactive Composite Resin Containing Silver/Zinc Oxide (Ag/ZnO) Nanoparticles as an Antimicrobial Material against Streptococcus mutans, Lactobacillus, and Candida albicans. Evid.-Based Complement. Altern. Med. 2021, 2021, 4743411. [Google Scholar] [CrossRef]
- Chang, Y.; Huang, H.; Chen, H.; Lai, C.; Wen, C. Antibacterial properties and cytocompatibility of tantalum oxide coatings. Surf. Coat. Technol. 2014, 259, 193. [Google Scholar] [CrossRef]
- Ardeshna, A.; Chavan, K.; Prakasam, A.; Ardeshna, D.; Shah, D.; Velliyagounder, K. Effectiveness of Different Sterilization Methods on Clinical Orthodontic Materials. J. Indian Orthod. Soc. 2023, 57, 98–105. [Google Scholar] [CrossRef]
- Wadhwa, P.; Sharma, S.; Sahu, S.; Sharma, A.; Kumar, D. A Review of Nanoparticles Characterization Techniques. Curr. Nanomater. 2022, 7, 202–214. [Google Scholar] [CrossRef]
- Cao, Y.; Zhou, C. Thickness dependence of surface roughness and magnetic properties of FeNiCr thin films. J. Magn. Magn. Mater. 2013, 333, 1–7. [Google Scholar] [CrossRef]
- Rohlf, J.W. Modern Physics from α to Z; John Wiley & Sons: Hoboken, NJ, USA, 1994; p. 20. [Google Scholar]
- Transition Metal Elements. 2022. Available online: https://www.thermofisher.com/iq/en/home/materials-science/learning-center/periodic-table/transition-metal.html (accessed on 20 June 2022).
- Pujahari, R. Solar Cell Technology. Energy Materials; Science Direct; Elsevier: Amsterdam, The Netherlands, 2021. [Google Scholar]
- Mukhtiar, S.; Yogita, S.; Hitesh, V.; Maninder, S. Various sputtered coating deposition techniques for the development of boron nitride based thin film coating: A review. AIP Publ. 2024, 2986, 020008. [Google Scholar]
- Vashista, M.; Soumitra, P. Correlation between full width at half maximum (FWHM) of XRD peak with residual stress on ground surfaces. Philos. Mag. 2012, 92, 4194–4204. [Google Scholar] [CrossRef]
- Vimbela, G.; Ngo, S.; Fraze, C.; Yang, L.; Stout, D. Antibacterial Properties and Toxicity from Metallic Nanomaterials. Int. J. Nanomed. 2017, 12, 3941–3965. [Google Scholar] [CrossRef] [PubMed]
- Nocito, G.; Sciuto, E.; Franco, D.; Nastasi, F.; Pulvirenti, L.; Petralia, S.; Spinella, C.; Calabrese, G.; Guglielmino, S.; Conoci, S. Physicochemical Characterization and Antibacterial Properties of Carbon Dots from Two Mediterranean Olive Solid Waste Cultivars. Nanomaterials 2022, 12, 885. [Google Scholar] [CrossRef] [PubMed]
- Agnihotri, S.; Dhiman, N. Development of Nano-Antimicrobial Biomaterials for Biomedical Applications. In Advances in Biomaterials for Biomedical Applications; Tripathi, A., Melo, J.S., Eds.; Advanced Structured Materials; Springer: Singapore, 2017; pp. 479–545. [Google Scholar]
- Da Silva, B.; Caetano, B.; Chiari-Andréo, B.; Linhari Rodrigues, R.; Chiavacci, L. Increased Antıbacterial Activity of Zno Nanoparticles: Influence of Size and Surface Modification. Colloids Surf. B Biointerfaces 2019, 117, 440–447. [Google Scholar] [CrossRef]
- Joy, G.; Ananthalakshmi, R.; Vidhya, K. Antibacterial Activity of Biofabricated Molybdenum Nanoparticles. J. Sci. Ind. Res. 2021, 80, 681–684. [Google Scholar]
- Huang, H.L.; Chang, Y.Y.; Chen, H.J.; Chou, Y.K.; Lai, C.H.; Chen, M.Y. Antibacterial properties and cytocompatibility of tantalum oxide coatings with different silver content. J. Vac. Sci. Technol. A 2014, 32, 02B117. [Google Scholar] [CrossRef]
- Seenaa, K.; Bilal, K.; Mohammed, K. Antibacterial activity of NiTi alloy with sputtered tantalum. J. Univ. Anbar Pure Sci. 2023, 17, 210–224. [Google Scholar]
- Yan, S.; Tuozhou, L.; Hongkun, H.; Zixuan, X.; Kai, Z.; Xi, H.; Wenbin, L.; Pengfei, L.; Yihe, H. Differential effect of tantalum nanoparticles versus tantalum micron particles on immune regulation. Mater. Today Bio 2022, 16, 100340. [Google Scholar]
- Kasraei, S.; Sami, L.; Hendi, S.; AliKhani, M.; Rezaei-Soufi, L.; Khamverdi, Z. Antibacterial properties of composite resins incorporating silver and zinc oxide nanoparticles on Streptococcus mutans and Lactobacillus. Restor. Dent. Endod. 2014, 39, 109–114. [Google Scholar] [CrossRef] [PubMed]
- Siddiqi, K.; Husen, A. Properties of zinc oxide nanoparticles and their activity against microbes. Nanoscale Res. Lett. 2018, 13, 141. [Google Scholar] [CrossRef]
- Mishra, P.; Mishra, H.; Ekielski, A.; Talegaonkar, S.; Vaidya, B. Zinc Oxide Nanoparticles: A Promising Nanomaterial for Biomedical Applications. Drug Discov. Today. 2017, 22, 1825–1834. [Google Scholar] [CrossRef]

| Nanomaterial | Elements (wt.%) | T1 | T2 | T3 |
|---|---|---|---|---|
| Mo | Mo | 6.6 | 8.0 | 8.3 |
| Fe | 56.3 | 53.0 | 52.7 | |
| Ta | Ta | 28.5 | 53.5 | 63.0 |
| Fe | 37.0 | 14.2 | 8.3 | |
| ZnO | ZnO | 10.6 | 25.6 | 30.2 |
| Fe | 50.8 | 36.8 | 33.1 |
| Type | Bacteria | Time | ANOVA (p Value) | Tukey HSD | ||||
|---|---|---|---|---|---|---|---|---|
| T1 | T2 | T3 | T1, T2 | T1, T3 | T2, T3 | |||
| Mo | Streptococcus mutans | 24.6 ± 3.9 | 24.3 ± 4.4 | 24.7 ± 8.1 | 0.99 | 0.99 | 0.99 | 0.99 |
| Lactobacillus acidophilus | 13.2 ± 5.04 | 13.4 ± 4.6 | 14.2 ± 4.8 | 0.9 | 0.9 | 0.9 | 0.9 | |
| Ta | Streptococcus mutans | 8.2 ± 6.12 | 10.6 ± 5.6 | 19.8 ± 5.2 | 0.8 | 0.8 | 0.008 | 0.03 |
| Lactobacillus acidophilus | 2.7 ± 7.6 | 10.3 ± 4.7 | 15.7 ± 5.3 | 0.09 | 0.09 | 0.005 | 0.3 | |
| ZnO | Streptococcus mutans | 27.4 ± 7.1 | 46.4 ± 5.2 | 72.1 ± 10.8 | 0.0001 | 0.0003 | 0.00001 | 0.00003 |
| Lactobacillus acidophilus | 25.95 ± 6.9 | 39.4 ± 8.5 | 67.9 ± 6.6 | 0.0001 | 0.05 | 0.0001 | 0.0001 | |
Disclaimer/Publisher’s Note: The statements, opinions and data contained in all publications are solely those of the individual author(s) and contributor(s) and not of MDPI and/or the editor(s). MDPI and/or the editor(s) disclaim responsibility for any injury to people or property resulting from any ideas, methods, instructions or products referred to in the content. |
© 2024 by the authors. Licensee MDPI, Basel, Switzerland. This article is an open access article distributed under the terms and conditions of the Creative Commons Attribution (CC BY) license (https://creativecommons.org/licenses/by/4.0/).
Share and Cite
Al-Mayali, A.M.Y.; Kadhum, A.S.; Alzubaydi, T.L. The Effects of Three Antibacterial Nanoparticle Coatings on the Surface Characteristics of Stainless Steel. Metals 2024, 14, 853. https://doi.org/10.3390/met14080853
Al-Mayali AMY, Kadhum AS, Alzubaydi TL. The Effects of Three Antibacterial Nanoparticle Coatings on the Surface Characteristics of Stainless Steel. Metals. 2024; 14(8):853. https://doi.org/10.3390/met14080853
Chicago/Turabian StyleAl-Mayali, Ahmed Muhsin Yousif, Ammar S. Kadhum, and Thair L. Alzubaydi. 2024. "The Effects of Three Antibacterial Nanoparticle Coatings on the Surface Characteristics of Stainless Steel" Metals 14, no. 8: 853. https://doi.org/10.3390/met14080853
APA StyleAl-Mayali, A. M. Y., Kadhum, A. S., & Alzubaydi, T. L. (2024). The Effects of Three Antibacterial Nanoparticle Coatings on the Surface Characteristics of Stainless Steel. Metals, 14(8), 853. https://doi.org/10.3390/met14080853

